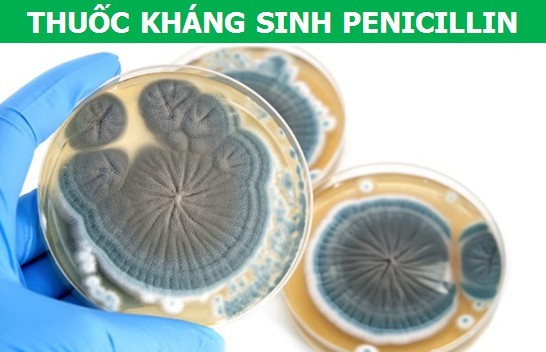

Sự khám phá ra Insulin được coi là một trong những bước tiến lớn nhất của nền y học thế giới. Trước đó, những người bị mắc căn bệnh tiểu đường thường phải chết trẻ, vì không hề có phương pháp chữa trị hữu hiệu. Công lao lớn này thuộc về hai nhà khoa học người Canada là Frederick G. Banting và Charles H. Best. Vào khoảng thập niên 30 của thế kỷ trước, hai nhà khoa học này đã khám phá ra loại hormone mà cơ thể dùng để phân giải đường, nhằm điều hòa chỉ số đường huyết, được tiết ra bởi tuyến Tụy là Insulin. Tiếp đó, họ đã thành công trong việc chiết xuất hoạt chất này từ động vật. Cho đến nay, đã có hàng tỷ sinh mạng trên thế giới được cứu sống nhờ phát hiện vĩ đại này.

Vào đầu những năm 20 của thế kỷ trước, nhà khoa học người Áo Ludwig Haberlandt đã có một công bố khoa học, mà sau này góp công rất lớn trong việc kiểm soát dân số thế giới. Theo đó, ông phát hiện ra rằng, các loại hormones có khả năng ngăn cản việc thụ thai ở động vật hết sức hữu hiệu. Tuy nhiên, khi chưa thể hiện thực hóa ý tưởng của mình, Haberlandt đã tự tử vào năm 1932 vì chịu quá nhiều áp lực từ dư luận, những người cho rằng tránh thai là một việc “vô đạo” , trái với tự nhiên. Được biết, phải đến 2 thập kỷ sau, loại thuốc tránh thai đầu tiên, kế thừa thành tựu của Ludwig Haberlandt, mới được ra đời tại Mỹ, thời điểm đó là vào năm 1960.
Có thể nói rằng, thuốc kháng sinh chính là khám phá lớn nhất của nền y học thế giới, bởi nó đã và đang cứu sống sinh mạng của của hàng trăm triệu người mỗi năm, khỏi bệnh nhiễm trùng. Cha đẻ của thuốc kháng sinh chính là nhà vi khuẩn học người Scotland, Alexander Fleming. Cụ thể, vào năm 1928, khi đang kiểm tra những đĩa nuôi vi khuẩn của mình, ông đã tình cờ phát hiện một vài chiếc đĩa bị nhiễm nấm mốc. Điều kỳ lạ là trong số đĩa này, vi khuẩn đã ăn lan khắp bề mặt chỉ trừ khu vực xung quanh các mảng nấm mốc. Đi sâu vào nghiên cứu, Alexander Fleming đã khám phá ra một hoạt chất từ nấm mốc, có thể tiêu diệt được vi khuẩn và đặt tên nó là Penicillin. Sau đó không lâu, hai nhà khoa học Howard Walter Florey và Ernst Boris Chain đã chiết xuất và tinh chế thành công Penicillin thành phương thuốc kháng sinh đầu tiên của thế giới.

Cuộc chiến của y học thế giới với căn bệnh thế kỷ HIV/AIDS cho tới nay vẫn hết sức cam go. Mặc dù chưa tìm được cách chữa dứt điểm căn bệnh do virut gây ra này, nhưng từ năm 1987, một loại thuốc có khả năng kéo dài đáng kể sự sống của người bệnh cũng đã được ra đời. Loại thuốc này có tên Zidovudine hay AZT. Về nguyên tắc hoạt động, AZT là chất ức chế quá trình phiên mã ngược, vốn là cách mà virut HIV dùng để nhân lên số lượng, trong cơ thể người. Từ đó, kiềm chế sự sinh sôi của tác nhân gây bệnh này. Nhờ có sự ra đời của AZT, số lượng người tử vong vì AIDS đã giảm đáng kể vào đầu thế kỷ 21. Chính vì vậy, AZT xứng đáng là một trong những loại thuốc làm thay đổi lịch sử nhân loại.









